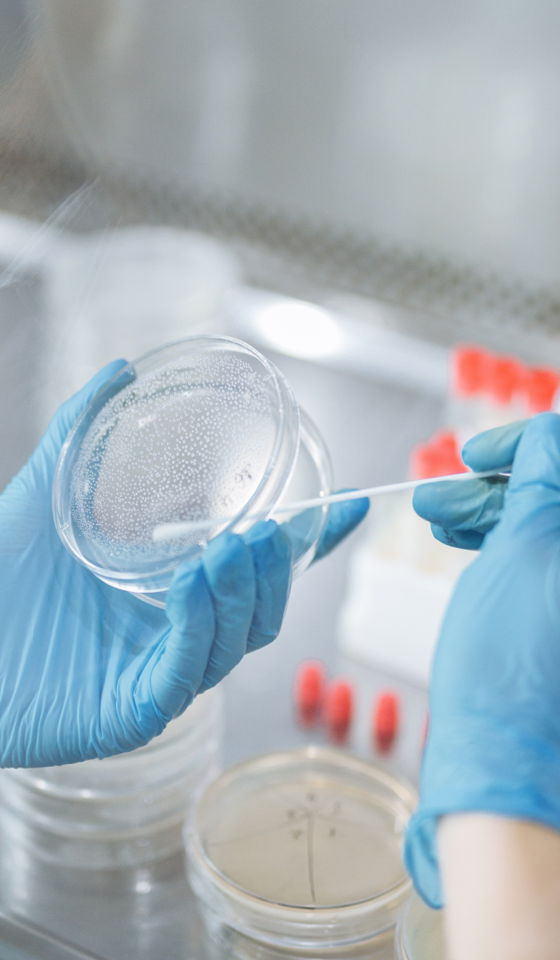

关于WINGWELL
连接并激发每一份医学价值

上海翼汇智创数字科技有限公司(WINGWELL)专注中国生命健康领域,以独创的数字
化学术推广和运营平台,为药械企业提供创新型推广解决方案,助力深耕县域下沉市场。

化学术推广和运营平台,为药械企业提供创新型推广解决方案,助力深耕县域下沉市场。

上海翼汇智创的创新型双线“虚拟代表”,切入行业核心业务环节,基于行业专有数据构建
的市场、医疗机构、医疗专业人士多维度标签,精准匹配潜力目标,通过数字化线上和
网格化线下,达成真实有效的双线连接,快速实现下沉市场的深入覆盖。
的市场、医疗机构、医疗专业人士多维度标签,精准匹配潜力目标,通过数字化线上和
网格化线下,达成真实有效的双线连接,快速实现下沉市场的深入覆盖。
成立至今,双线“虚拟代表“,已与多家国内外知名医药品牌成功合作,90%为世界500
药械企业和国内上市企业,重点覆盖呼吸科、感染科、心内科、肾内科、儿科、妇产
科、骨科、消化科、精神科、神经内科等科室等多个疾病领域。
药械企业和国内上市企业,重点覆盖呼吸科、感染科、心内科、肾内科、儿科、妇产
科、骨科、消化科、精神科、神经内科等科室等多个疾病领域。
上海翼汇智创核心团队致力于中国生命健康领域数字化转型15年,服务过将近300家药械
品牌。深刻理解市场发展趋势和政策导向,贴近企业核心业务,洞察行业需求。
以专业的解决方案和成功的客户运营与行业一起成长向前。
品牌。深刻理解市场发展趋势和政策导向,贴近企业核心业务,洞察行业需求。
以专业的解决方案和成功的客户运营与行业一起成长向前。
提供高质量的医疗数据和最新研究成果,涵盖多个关键科室,包括妇科、儿科、骨科、眼科、呼吸科和肾脏科等
关注下列公众号获取详细内容
关注下列公众号获取详细内容











Cooperation Cases
我们的合作案例





Wingwell has passed many authoritative certifications to provide customers with safety and compliance services
WINGWELL拥有专业准入资质,通过管理体系认证,
保障服务的安全合规
保障服务的安全合规





Copyright © 翼汇智创 All Rights Reserved. 备案号:沪ICP备2022004941号-2

 021-34161668
021-34161668









